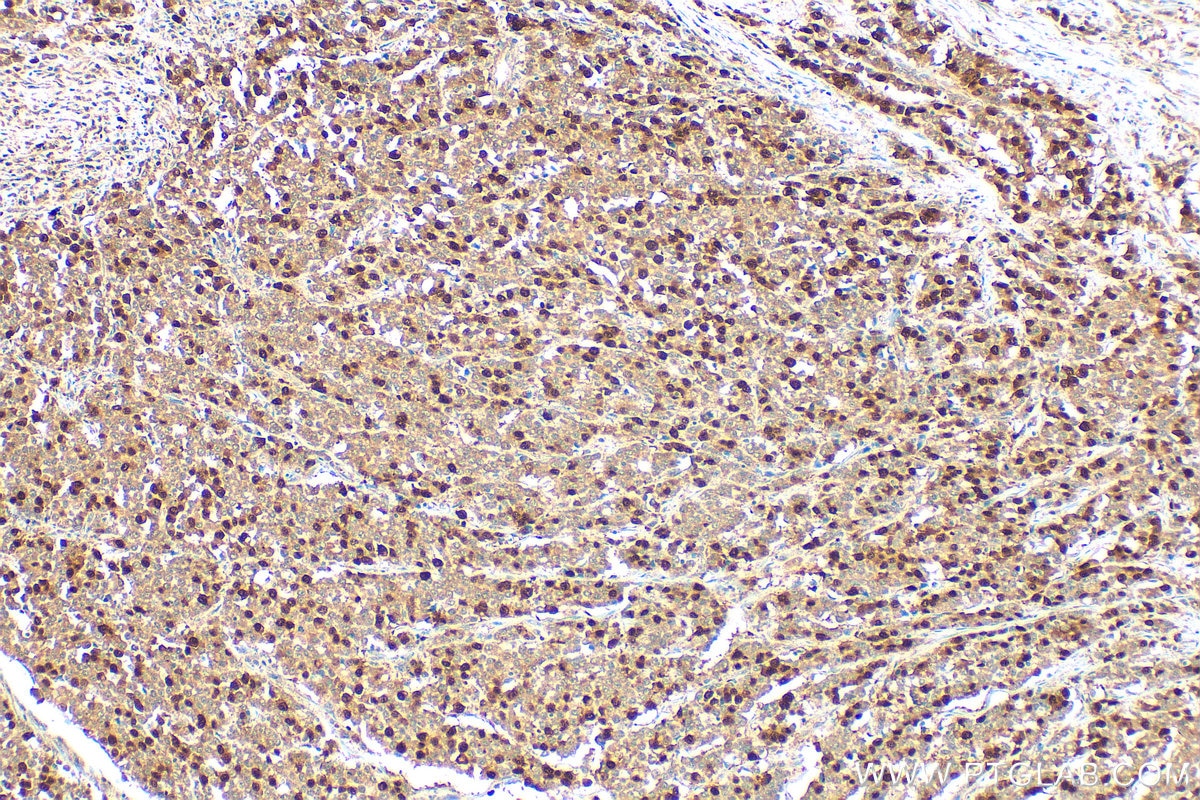
Immunohistochemical analysis of paraffin-embedded human colon cancer tissue slide using 18202-1-AP (Cyclin A2 antibody) at dilution of 1:1000 (under 10x lens). Heat mediated antigen retrieval with Tris-EDTA buffer (pH 9.0). Immunohistochemistry (IHC) staining of human colon cancer tissue using Cyclin A2 Polyclonal antibody (18202-1-AP)

Tested Applications
| Positive WB detected in | HL-60 cells, K-562 cells, U-937 cells, HeLa cells, NIH/3T3 cells, MCF-7 cells |
| Positive IP detected in | HeLa cells, HL-60 cells |
| Positive IHC detected in | human tonsillitis tissue, human breast cancer tissue, human colon cancer tissue Note: suggested antigen retrieval with TE buffer pH 9.0; (*) Alternatively, antigen retrieval may be performed with citrate buffer pH 6.0 |
| Positive IF/ICC detected in | HepG2 cells, MCF-7 cells |
| Positive FC (Intra) detected in | HeLa cells |
Recommended dilution
| Application | Dilution |
|---|---|
| Western Blot (WB) | WB : 1:5000-1:50000 |
| Immunoprecipitation (IP) | IP : 0.5-4.0 ug for 1.0-3.0 mg of total protein lysate |
| Immunohistochemistry (IHC) | IHC : 1:500-1:2000 |
| Immunofluorescence (IF)/ICC | IF/ICC : 1:200-1:800 |
| Flow Cytometry (FC) (INTRA) | FC (INTRA) : 0.40 ug per 10^6 cells in a 100 µl suspension |
| It is recommended that this reagent should be titrated in each testing system to obtain optimal results. | |
| Sample-dependent, Check data in validation data gallery. | |
Published Applications
| KD/KO | See 2 publications below |
| WB | See 197 publications below |
| CoIP | See 1 publications below |
Product Information
18202-1-AP targets Cyclin A2 in WB, FC (Intra), IP, CoIP, ELISA applications and shows reactivity with human, mouse samples.
| Tested Reactivity | human, mouse |
| Cited Reactivity | human, mouse, rat, pig, monkey |
| Host / Isotype | Rabbit / IgG |
| Class | Polyclonal |
| Type | Antibody |
| Immunogen |
CatNo: Ag12765 Product name: Recombinant human Cyclin A2 protein Source: e coli.-derived, PGEX-4T Tag: GST Domain: 1-432 aa of BC104783 Sequence: MLGNSAPGPATREAGSALLALQQTALQEDQENINPEKAAPVQQPRTRAALAVLKSGNPRGLAQQQRPKTRRVAPLKDLPVNDEHVTVPPWKANSKQPAFTIHVDEAEKEAQKKPAESQKIEREDALAFNSAISLPGPRKPLVPLDYPMDGSFESPHTMDMSIVLEDEKPVSVNEVPDYHEDIHTYLREMEVKCKPKVGYMKKQPDITNSMRAILVDWLVEVGEEYKLQNETLHLAVNYIDRFLSSMSVLRGKLQLVGTAAMLLASKFEEIYPPEVAEFVYITDDTYTKKQVLRMEHLVLKVLTFDLAAPTVNQFLTQYFLHQQPANCKVESLAMFLGELSLIDADPYLKYLPSVIAGAAFHLALYTVTGQSWPESLIRKTGYTLESLKPCLMDLHQTYLKAPQHAQQSIREKYKNSKYHGVSLLNPPETLNL Predict reactive species |
| Full Name | cyclin A2 |
| Calculated Molecular Weight | 432 aa, 49 kDa |
| Observed Molecular Weight | 48-52 kDa |
| GenBank Accession Number | BC104783 |
| Gene Symbol | Cyclin A2 |
| Gene ID (NCBI) | 890 |
| RRID | AB_10597084 |
| Conjugate | Unconjugated |
| Form | Liquid |
| Purification Method | Antigen affinity purification |
| UNIPROT ID | P20248 |
| Storage Buffer | PBS with 0.02% sodium azide and 50% glycerol, pH 7.3. |
| Storage Conditions | Store at -20°C. Stable for one year after shipment. Aliquoting is unnecessary for -20oC storage. 20ul sizes contain 0.1% BSA. |
Background Information
Cyclin A2 belongs to the highly conserved cyclin family, whose members are characterized by a dramatic periodicity in protein abundance through the cell cycle. Cyclins function as regulators of CDK kinases. Different cyclins exhibit distinct expression and degradation patterns which contribute to the temporal coordination of each mitotic event. In contrast to cyclin A1, which is present only in germ cells, this cyclin is expressed in all tissues tested. Cyclin A2 binds and activates CDC2 or CDK2 kinases, and thus promotes both cell cycle G1/S and G2/M transitions. Cyclin A2 could be phosphorylated during the G2/M.
Protocols
| Product Specific Protocols | |
|---|---|
| IF protocol for Cyclin A2 antibody 18202-1-AP | Download protocol |
| IHC protocol for Cyclin A2 antibody 18202-1-AP | Download protocol |
| IP protocol for Cyclin A2 antibody 18202-1-AP | Download protocol |
| WB protocol for Cyclin A2 antibody 18202-1-AP | Download protocol |
| Standard Protocols | |
|---|---|
| Click here to view our Standard Protocols |
Publications
| Species | Application | Title |
|---|---|---|
Nat Metab LIFR regulates cholesterol-driven bidirectional hepatocyte-neutrophil cross-talk to promote liver regeneration | ||
Mol Cell A di-acetyl-decorated chromatin signature couples liquid condensation to suppress DNA end synapsis | ||
Mol Cancer CircEZH2/miR-133b/IGF2BP2 aggravates colorectal cancer progression via enhancing the stability of m6A-modified CREB1 mRNA. | ||
Acta Pharm Sin B The substitution of SERCA2 redox cysteine 674 promotes pulmonary vascular remodeling by activating IRE1α/XBP1s pathway. | ||
Sci Adv The p23 co-chaperone is a succinate-activated COX-2 transcription factor in lung adenocarcinoma tumorigenesis |